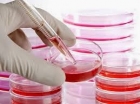
Imagem Notícia

Vimos por meio desta lhe fala um pouco sobre uma doença rara e pouco conhecida, a Esclerose Lateral Amiotrófica (ELA), e lhe apresenta a nossa pauta de revindicações mais urgentes. A ELA é uma doença neuromuscular, de caráter progressivo e degenerativo, sem cura ou tratamento eficaz, que acomete cerca de 1 a 2 pessoas/100.000 habitantes, começando pelo acometimento dos membros inferiores e superiores, aparelho digestivo e respiratório, causando tetraplegia, disartria, disfagia e comprometimento respiratório, e numa fase mais avançada, a necessidade de realização de traqueostomia para uso de ventilação assistida, e gastrostomia, para que o paciente possa se alimentar através de sonda endogástrica...
Leia Mais